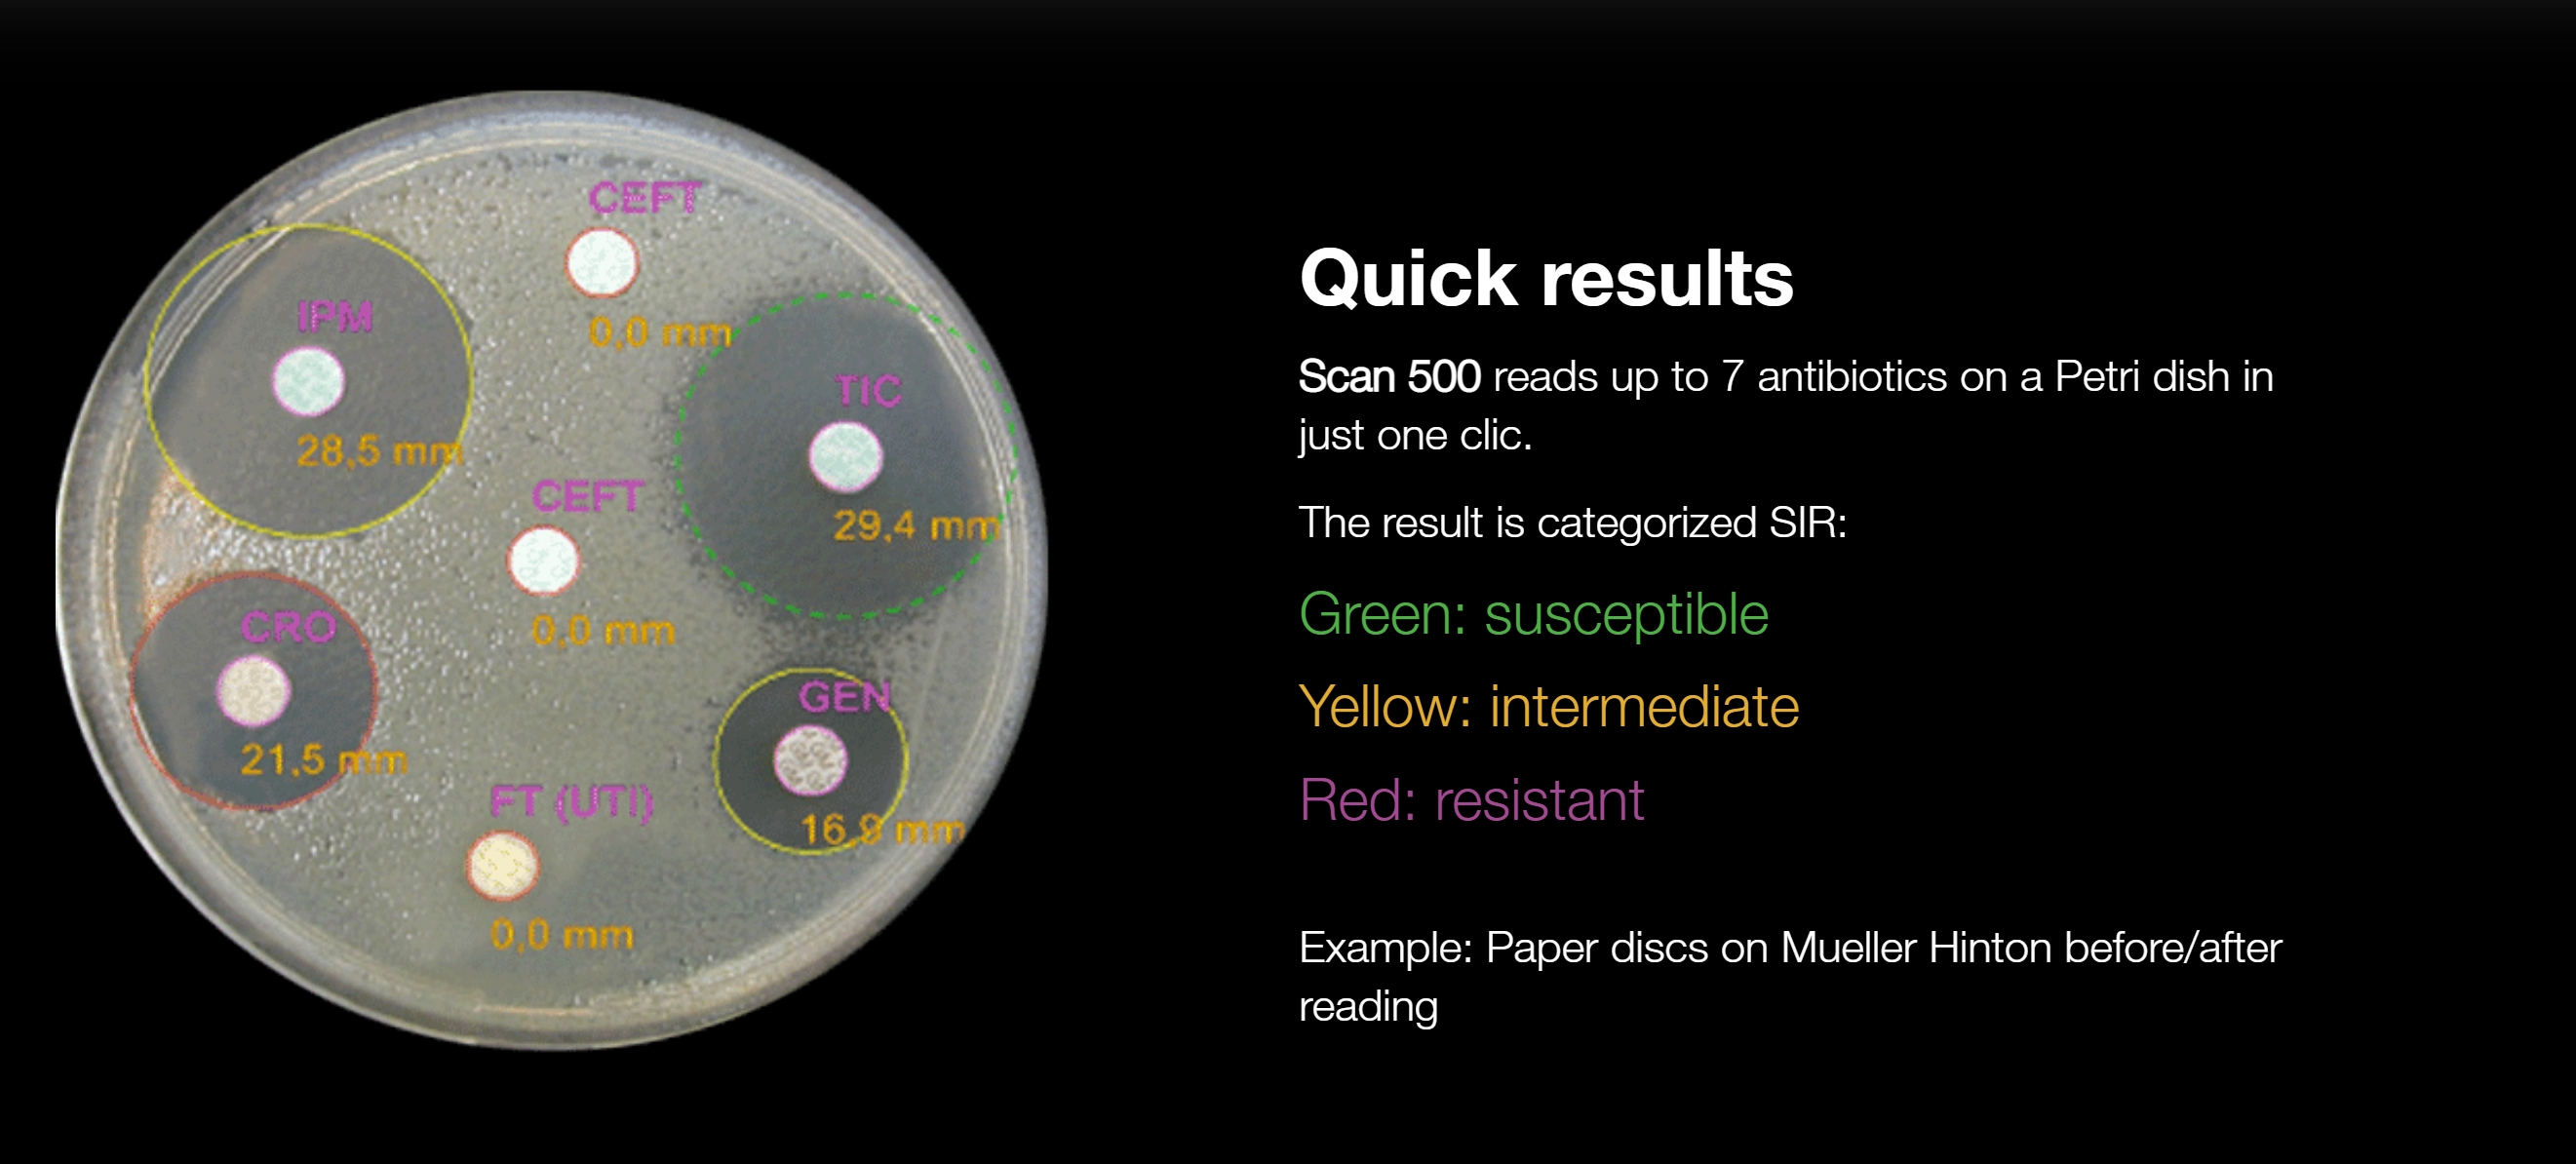

Scan 500
Inhibition zone reader
Essential features
Scan 500 is an inhibition zone reader. It has been designed for the pharmaceutical industries, medical research and animal health. Scan 500 also counts colonies on Petri dishes.
- Inhibition zone measurement accuracy: ± 0,3 mm
- Fast: up to 7 inhibition zones in 1 click
- Protocols: wells, peni-cylinders, paper disks
- Interpretation systems: EUCAST, CA-SFM, CLSI and customizable
Detection on all dishes
Scan 500 automatically detects the peni-cylinders, present or removed, made of steel or plastic. It also reads agar wells or paper disks (any brand). Add/remove disks manually. The inhibition zones can also be resized. Scan 500 allows reading on blood, chocolate or Mueller Hinton agar. In colony counter mode, it counts on round Petri dishes.

21 CFR Part 11 included
The Scan software complies with FDA recommendations, particularly on audit trail and security of results. The user account management, integrated in the software, allows the creation of up to 5 levels of rights. The Supervisor-Administrator has all the roles while the other roles are subject to certain rights. Password management secures user accounts.
Traceability
1. Data Import
Scan 500 connects to the LIMS in bi-directionality and can be connected to the diluter and plater via dataLink traceability system.
3. Data Export
Scan 500 offers multiple export possibilities to save manual input time. It also increases the security and quality of your analyses. Usually, Petri dishes are thrown away after counting and no further verification is possible in the event of a claim. With Scan 500, all reports are archivedExport your results to your PC or archive them in CSV, ExcelTM, OpenOfficeTM, PDF, SCA, BIO format. You can also export images from the camera in JPEG, PNG and BMP format.
Print of the results
All data, images, photos and results are exportable in printable reports, sca, pdf, jpg, xls, csv.
Integrated databases
The Scan software is equipped with a database of antibiotics from the French Society of Microbiology (CA-SFM 2020), the European Committee of Antibiograms (EUCAST 2020), the Clinical and Laboratory Standards Institute (CLSI). This database can be modified by the user.

Applications
The Scan 500 colony counter is used in the food, environmental, pharmaceutical, cosmetics, veterinary and public institutes research.

Scan Range Brochure Scan 500 Inhibition Zone Reader Technical File